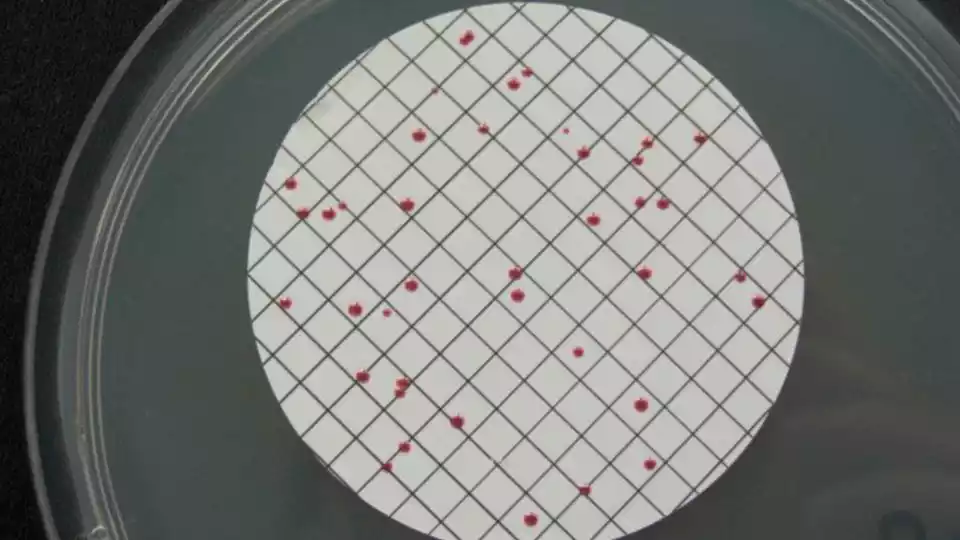
Enterococos. Vista microscópica

En el Pleno del Ayuntamiento de Illescas de ayer 29-12-25, y en el turno de ruegos y preguntas intervenía la concejala de Vox María de la Fe López. En su turno la concejala se refería a la existencia en la página web de Aqualia de dos informes de calidad del agua de este año en los cuales se especificaba que el agua de Illescas estaba calificada como «AGUA NO APTA PARA EL CONSUMO».
Especificaba además que existían dos boletines de análisis de calidad del agua que correspondían a el día 2 de Junio de 2.025 y otro del 28 de Abril de 2.025.
Revuelo en la oposición que causaba esta intervención de la concejala, que fue respondida por el concejal socialista Francisco Rodriguez que expresó su negativa a estos informes por incompletos, y calificó la información que daba la concejala de Vox como «rotundamente falso» que el agua de Illescas no fuera apta para el consumo.
En illescasaldia.com hemos investigado datos y documentos y encontramos lo siguiente y de lo que adjuntamos capturas o archivos descargables:
Existen dos boletines con números 16540671 y 16392422 emitidos por el SINAC (Sistema de Información Nacional de Aguas de Consumo), entidad dependiente del Ministerio de Sanidad. En dichos boletines se especifica claramente que la Calificación de la muestra indica «AGUA NO APTA PARA EL CONSUMO»
Detalles de los informes
Detalle del Boletin 16540671:
Fecha de toma e la muestra: 28/04/2025. La toma se efectuó en el punto de medición de la Red de la zona CENTRO-BAJA ILLESCAS. Fue un análisis completo en el que se encontró, según consta en el informe un valor anormal en los parámetros obligatorios. El valor era el que comprendía el sumatorio de los 5 AHAs. El nominal de este valor paramétrico es de 60 micro gramos x litro (µg/l) según se indica en el Real Decreto 3-2023 de Calidad del agua. La muestra fue analizada y los informes remitidos al SINAC por el laboratorio Aqualialab-Oviedo.
En dicho informe o boletín se indica que el valor obtenido en 5 AHAs es de 101 micro gramos x litro (µg/l), superando ampliamente el valor paramétrico. Es por esta medición por lo que se indica en el informe que el AGUA NO ES APTA PARA EL CONSUMO.
Que son los 5 AHAs:
Los 5 AHAs son unos ácidos subproductos de la desinfección con cloro y la presencia de estos en cierta cantidad conllevan riesgo para la salud. Los Ácidos Haloacéticos son los Ácidos Monocloroacético, Dicloroacético, Tricloroacético, Monobromoacético y Dibromoacético. La normativa europea y española también indican un límite en su totalidad de 60 µg/L para los 5 más importantes (suma 5 AHAs) en el agua de consumo humano.
Detalle del Boletin 16392422:
Fecha de toma de la muestra: 02/06/2025. La toma se efectuó en el punto de medición de la Red en el Señorío de Illescas. Fue un análisis de control en el que se encontró, según consta en el informe un valor anormal en los parámetros obligatorios. El valor era el contenido de «Enterococo». El nominal de este valor paramétrico llamado «enterococo intestinal» ha de ser 0 UFC/100 ml (Unidades Formadoras de Colonias x 100 mililitros) según se indica en el Real Decreto 3-2023 de Calidad del agua. La muestra fue analizada y los informes remitidos al SINAC por el laboratorio Aqualialab-Avila.
En dicho informe o boletín se indica que el valor obtenido en Enterococo es de 2 unidades UFC/100 ml, superando ampliamente el valor paramétrico que ha de ser 0. Es por esta medición por lo que se indica en el informe que el AGUA NO ES APTA PARA EL CONSUMO.
Que es el enterococo intestinal
Es una bacteria y forma parte de la microbiota normal del tracto gastrointestinal humano. Las especies más frecuentes en los aislamientos son E. faecalis y E. faecium.
Los enterococos también pueden estar presentes en suelo, alimentos, agua, plantas, animales e insectos y suelen considerarse buenos indicadores de contaminación fecal debido a que son muy resistentes a condiciones adversas. Su presencia está relacionada directamente con gastroenteritis, enfermedades respiratorias, conjuntivitis y dermatitis, entre otras.
Esta es la información detallada de los informes. No se tiene conocimiento de ninguna alerta ni por parte de la suministradora Aqualia ni por parte del Ayuntamiento de Illescas de estas dos situaciones.
Hay constancia de la existencia de estas alertas, porque es Aqualia quien toma las muestras, las manda a los laboratorios y estos estan obligados a enviar al SINAC los resultados periodicos de los analisis. Además esta documentación es pública y accesible.
Hay malestar, entre los ciudadanos y preocupación. Primero por la falta de transparencia de las entidades públicas y privadas sobre estas alarmas. Segundo por las subidas bestiales que se hace en los precios de un suministro vital, y encima que según los informes no esté en condiciones salubres en ciertos periodos. Tercero por el gasto en descalcificadores, garrafas de agua, botellas, etc. que tienen los vecinos. Y por último las numerosas incidencias comentadas por los ciudadanos sobre los malos olores y sabores del agua, turbidez, etc.
Seguiremos informando.